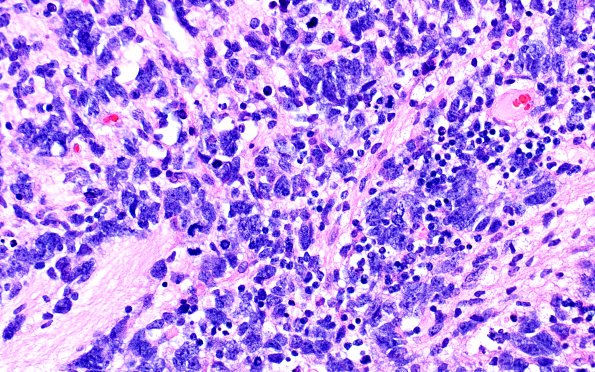
7A3 ETMR (Case 7) H&E 9

Table of Contents
Washington University Experience | NEOPLASMS (EMBRYONAL) | ETMR - Embryonal Tumor Multilayered Rosettes | 7A3 ETMR (Case 7) H&E 9
The tumor cells are arranged in solid sheets, pseudo-papillary, multilayered and pseudostratified neuroepithelium with a central lumen that is frequently filled with eosinophilic material. There are frequent mitoses, although no significant tumor necrosis. Some degree of differentiation into mature neuropil is present. The adjacent cerebellar parenchyma is well demarcated from the tumor. (H&E)